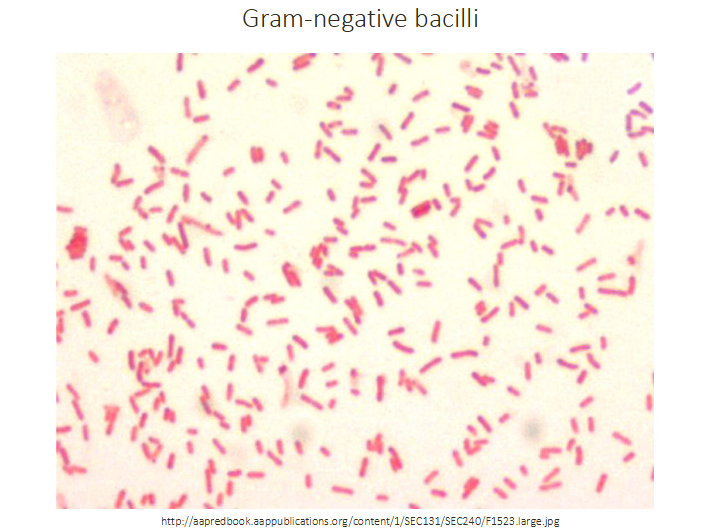
<p>Gram-negative bacilli</p>

1/29
Looks like no tags are added yet.
Name | Mastery | Learn | Test | Matching | Spaced | Call with Kai |
|---|
No analytics yet
Send a link to your students to track their progress
Why understanding bacterial genetics is important for a clinician
BACTERIAL GENES ENCODE ELEMENTS WHICH ARE IMPORTANT FOR:
- Virulence
- Antimicrobial Resistance
- Vaccine Design (antigens which stimulate specific immunity)
.
WE USE APPLIED BACTERIAL GENOMICS FOR:
- Molecular epidemiology (detecting outbreaks and tracking spread of strains)
- genetic engineering

Bacterial Genetic Material (Genome)
Bacterial chromosome is within the nucleoid region (no nucleus or nuclear membrane)
- circle of double-stranded DNA in most bacteria (a few bacteria have linear chromosome, some have more then one chromosome)
- size ranges from 130kb to more then 14Mb (average 4Mb)
- Supercoiling of DNA allows packaging (DNA gyrase enzyme responsible for coiling, inhibited by fluoroquinolone antibiotics)

Plasmids
MOST BACTERIA ALSO CONTAIN PLASMIDS:
- small, usually circular, double stranded extra chromosomal DNA
- replicate independently of the host chromosomes
.
carry genes which are not essential to the bacterium but may be useful in certain environments
- R plasmids encode antibiotic resistance genes
- plasmids may encode virulence genes
- Col plasmids encode bacteriocins (which inhibit growth of other bacteria)
- Conjugative plasmids encode sex pili
Genetic Basis of Variation in Bacteria
BACTERIA EVOLVE RAPIDLY DUE TO:
- short generation times (20 minutes to hours) (one cell can turn into millions of identical bacteria (a clonal population, seen on an agar plate as a single bacterial colony)
- strong selection pressures from: host immunity, other organisms present in the microbiome, antibiotics
.
GENETIC VARIATION OCCURS THROUGH TWO MECHANISMS:
- Vertical inheritance of random mutations
- Horizontal gene transfer
Vertical inheritance of mutations
MUTATIONS OCCUR AT A LOW FREQUENCY e.g 1 in million or billion cells
- because bacteria grow so rapidly, in a large bacterial population there will be many bacteria with mutations
.
TWO KINDS OF DNA MUTATIONS
- Point Mutations: change of a single nucleotide
- DNA rearrangements: insertions, deletions, inversions
.
MUTATION OUTCOMES:
- Deleterious: the population dies out by being taken over by wild type bacteria (without the mutation)
- Beneficial: mutation confers an advantageous function to the cell e.g antibiotic resistance. Under the appropriate conditions, this advantageous mutation will have a selective advantage and will overtake the other populations of bacteria
- Neutral or Silent: no obvious effect on phenotype
LEARN ABOUT MUTATIONS AGAIN FROM HBIO

Horizontal Gene Transfer in Bacteria DIAGRAM
- bacterial transformation is the abilty of some bacteria to take up free DNA from the environment
- Bacteriophages insert viral dNA into bacteiral chromosome so that it uses host machinery to replicate itself (when they do this, occasionally some DNA from the host can be picked up, and when the virus is relesaed it can be transferred to another host)


Small mobile genetic elements
MOBILE PIECES OF DNA ('jumping genes') which cut themselves out of chromosome or plasmids and insert into another part of the chromosome or plasmid
- Insertion Sequences (IS): very common, small fragments of DNA that only carry genes coding for enzymes required for transposition (transposition is movement of DNA between different DNA segments)
- Transposons: larger DNA fragments which carry structural genetic information (e.g for antibiotic resistance), typically flanked by insertion sequences


Small mobile genetic elements: integrons
integrons are genetic elements with the ability to capture genes (often encoding antibiotic resistance) into an 'expression cassette'
- the expression cassette includes a promoter sequence, which promotes the transcription of the genes in the integron
- integrons are often found within the structural gene segment of large transposons
- allow bacteria to adapt and evolve rapidly through the stockpiling and expression of new genes


The basic integron consists of
DONT NEED TO KNOW DETAILS, JUST NEED A BASIC UNDERSTANDING

The problem of bacterial classification
- Microbiologists face a daunting task of understanding the huge diversity of bacteria
- taxonomic assignment, in which bacteria are placed in a hierarchial arrangement, provides an organisational framework
- Historically, bacterial taxonomy was based on phenotype: morphological, physiological and ecological characteristics (this "phenetic" classification is still useful, but sometimes contradicts what we now know of the evolutionary relationships between organisms)
- Genotypic/phylogenetic classification systems are now used
- Bacteria are named according to the binomial system of Linnaeus: genus and species

Nomenclature (bacteria, fungi, parasites)
DIAGRAM ON SLIDE 13


Taxonomic Ranks
- groups at any rank level share common properties with the group they belong to in the rank above
.
- need to know this as this is a learning outcome. its called Bacterial Taxonomy


Genotypic vs Phenotypic Classification
DIAGRAM ON SLIDE 15


One central phenotypic property of bacteria that is often assessed is the requirement for O2
GROUP: Obligate aerobe
OXYGEN REQUIREMENT: Require atmospheric O2 (generate energy by respiration)
.
GROUP: Microaerophile
O2 REQUIRENMEBNT: Require 2-10% O2 i.e. lower than atmospheric
.
GROUP: Facultative anaerobe
O2 REQUIREMENT: Do not require O2 but grow better in its presence
.
GROUP: Aerotolerant anaerobe
O2 REQUIREMENT: Grow equally well in presence or absence of O2
.
GROUP: Obligate (strict) anaerobe
O2 REQUIREMENT: Killed by O2 - may gain energy by fermenting sugars
.
- bacterial pathogens include members of all these groups
- O2 requirement impacts on sites of bacterial colonisation and disease (e.g lower GIT vs airways)


The two most common shapes of bacteria are
coccus (pl. cocci) and rod (sometimes called bacillus/ pl. bacilli)


Other bacterial shapes include
- filamentous
- rigid spirals, flexible spirals
- comma-shaped rods
- pleiomorphic (variable, lacking a characteristic form)


The Gram stain (unstained smear (direct from a sample e.g pus or from a bacterial culture)
DIAGRAM ON SLIDE 19


Gram Stain stained with crystal violet
DIAGRAM ON SLIDE 20


Gram stain decolourised with acetone
- some organisms are unable to hold onto the purple stain)


Gram stain - counter stain with carbol fuschin
- gram positive cocci/bacilli are purple, gram negative cocci /bacilli are pink


The gram stain allows us to classify many organisms by their shape and staining properties
DIAGRAM ON SLIDE 23


We can further classify Gram positive cocci according to how they link up together
GRAM POSITIVE COCCI:
- In chains and pairs means streptococcus or enterococcus
- in clusters means staphylococcus


MEDICALL IMPORTANT BACTERIA
- dont need to know now but need to know in future


Gram positive cocci in chains (streptococci)
DIAGRAM ON SLIDE 26


Gram positive cocci in clusters (staphylococci)
DIAGRAM ON SLIDE 27


Gram-positive bacilli with terminal spores
e.g colstridium tetani
- look at the middle one it has a little bump on the terminal (end) its called having a terminal spore


Intracellular gram-negative diplococci
- Neisseria gonorrhea

Gram-negative bacilli
DIAGRAM ON SLIDE 30


Not all bacteria can be visualised with the gram stain EXAMPLE 1
- treponema pallidum (a spirochaete, or spiral bacterium) (the cause of syphillis)


Not all bacteria can be visualised with the gram stain EXAMPLE 2
- myobacterium tuberculosis (weakly gram-positive cell wall but waxy coat makes staining difficult; instead we use ACID FAST STAINS
